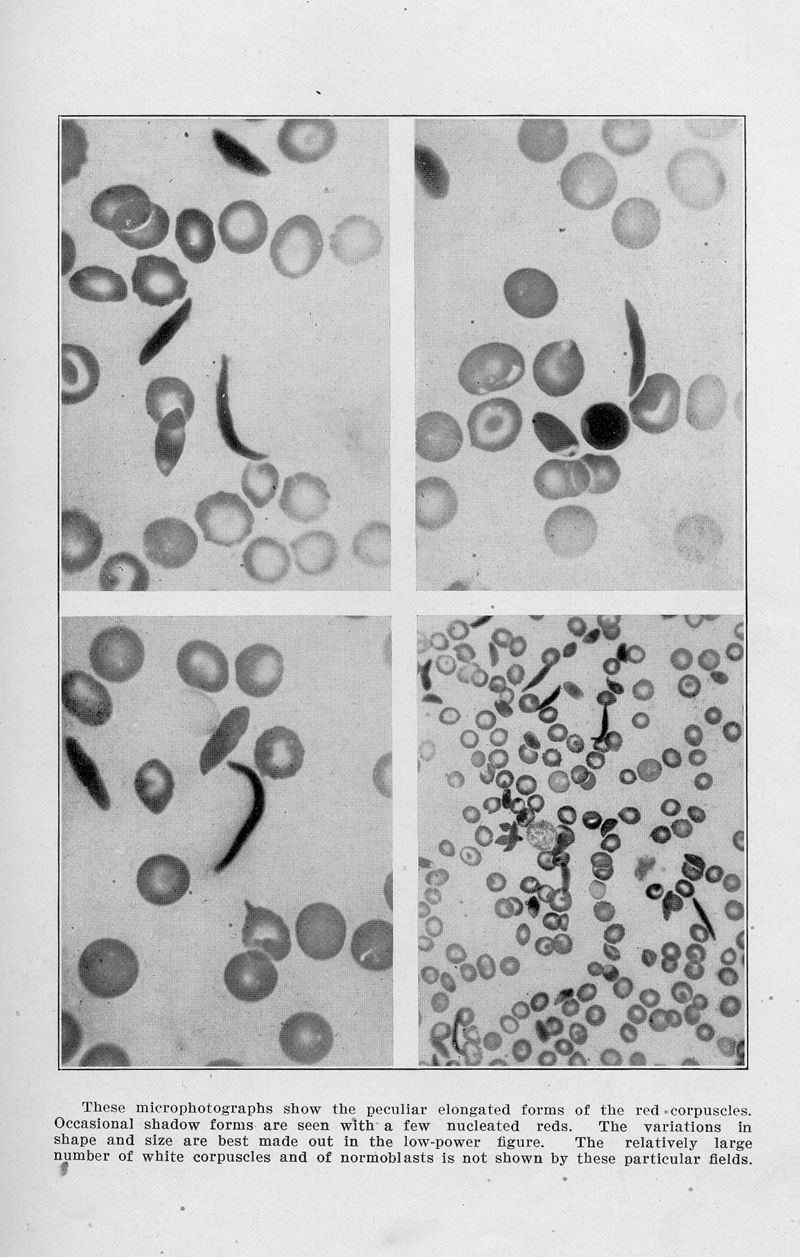

Présentation • Mode d’emploi • Services associés • Réutilisations
|
HERRICK, James Ryan.
In : Archives of internal medicine (1908),
1910, Vol. 6 pp. 517-21
|
|
|
|
HERRICK, James Ryan.
In : Archives of internal medicine (1908),
1910, Vol. 6 pp. 517-21
|